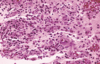

Chapter 3: Pulpal and Periapical Disease CPC Flashcards
(34 cards)

chronic hyperplastic pulpitis

chronic hyperplastic pulpitis

periapical abscess
what is the most common periapical pathosis?
periapical granuloma

periapical granuloma

periapical granuloma

periapical granuloma

periapical granuloma

periapical fibrous scar

periapical cyst

periapical cyst

periapical cyst
radioluscency extends from mandibular frist molare to the contralateral first molar

periapical cyst

lateral radicular cyst

lateral radicular cyst

residual periapical cyst

periapical abscess

periapical abscess

cutaneous sinus tract

intraoral sinus tract aka parulis aka gum boil
hint: this is an aggressive and rapidly spreading form of cellulitis that involves the sublingual, submandibular, and submental spaces bilaterally

ludwig angina

acute osteomyelitis

acute osteomyelitis with sequestrum

pulp stones